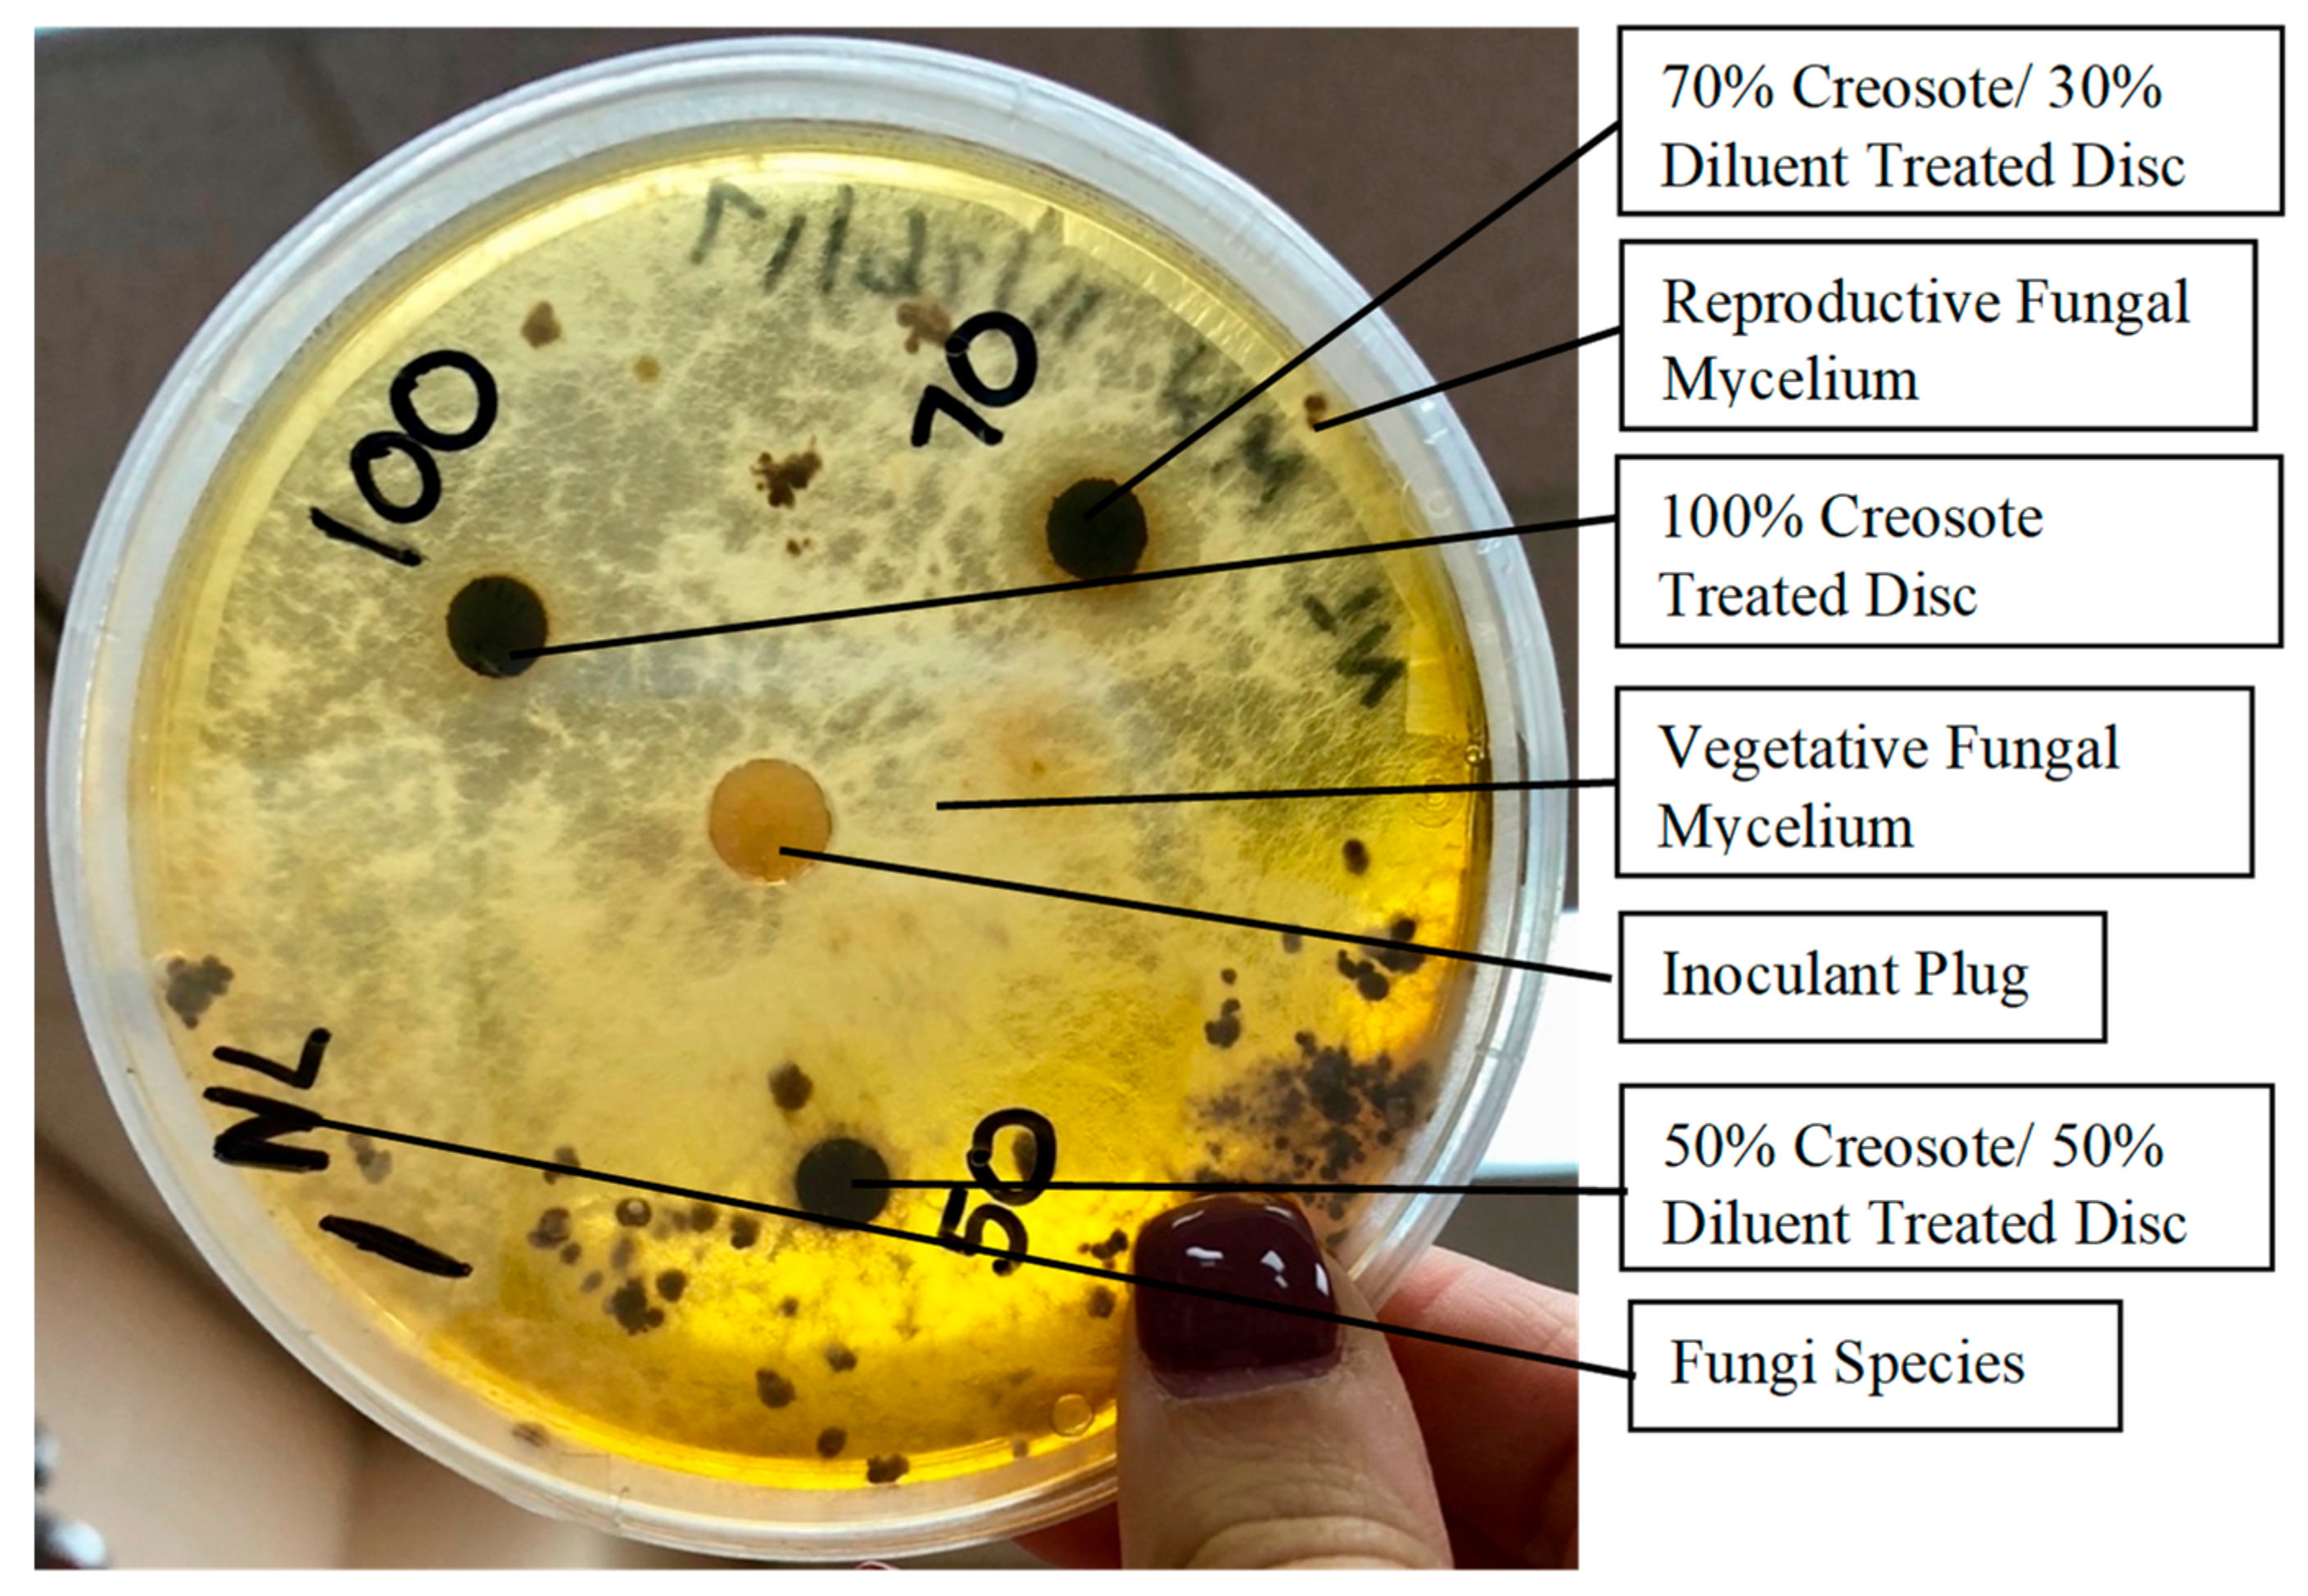
Forests 14 00625 g002 Forests 14 00625 g002
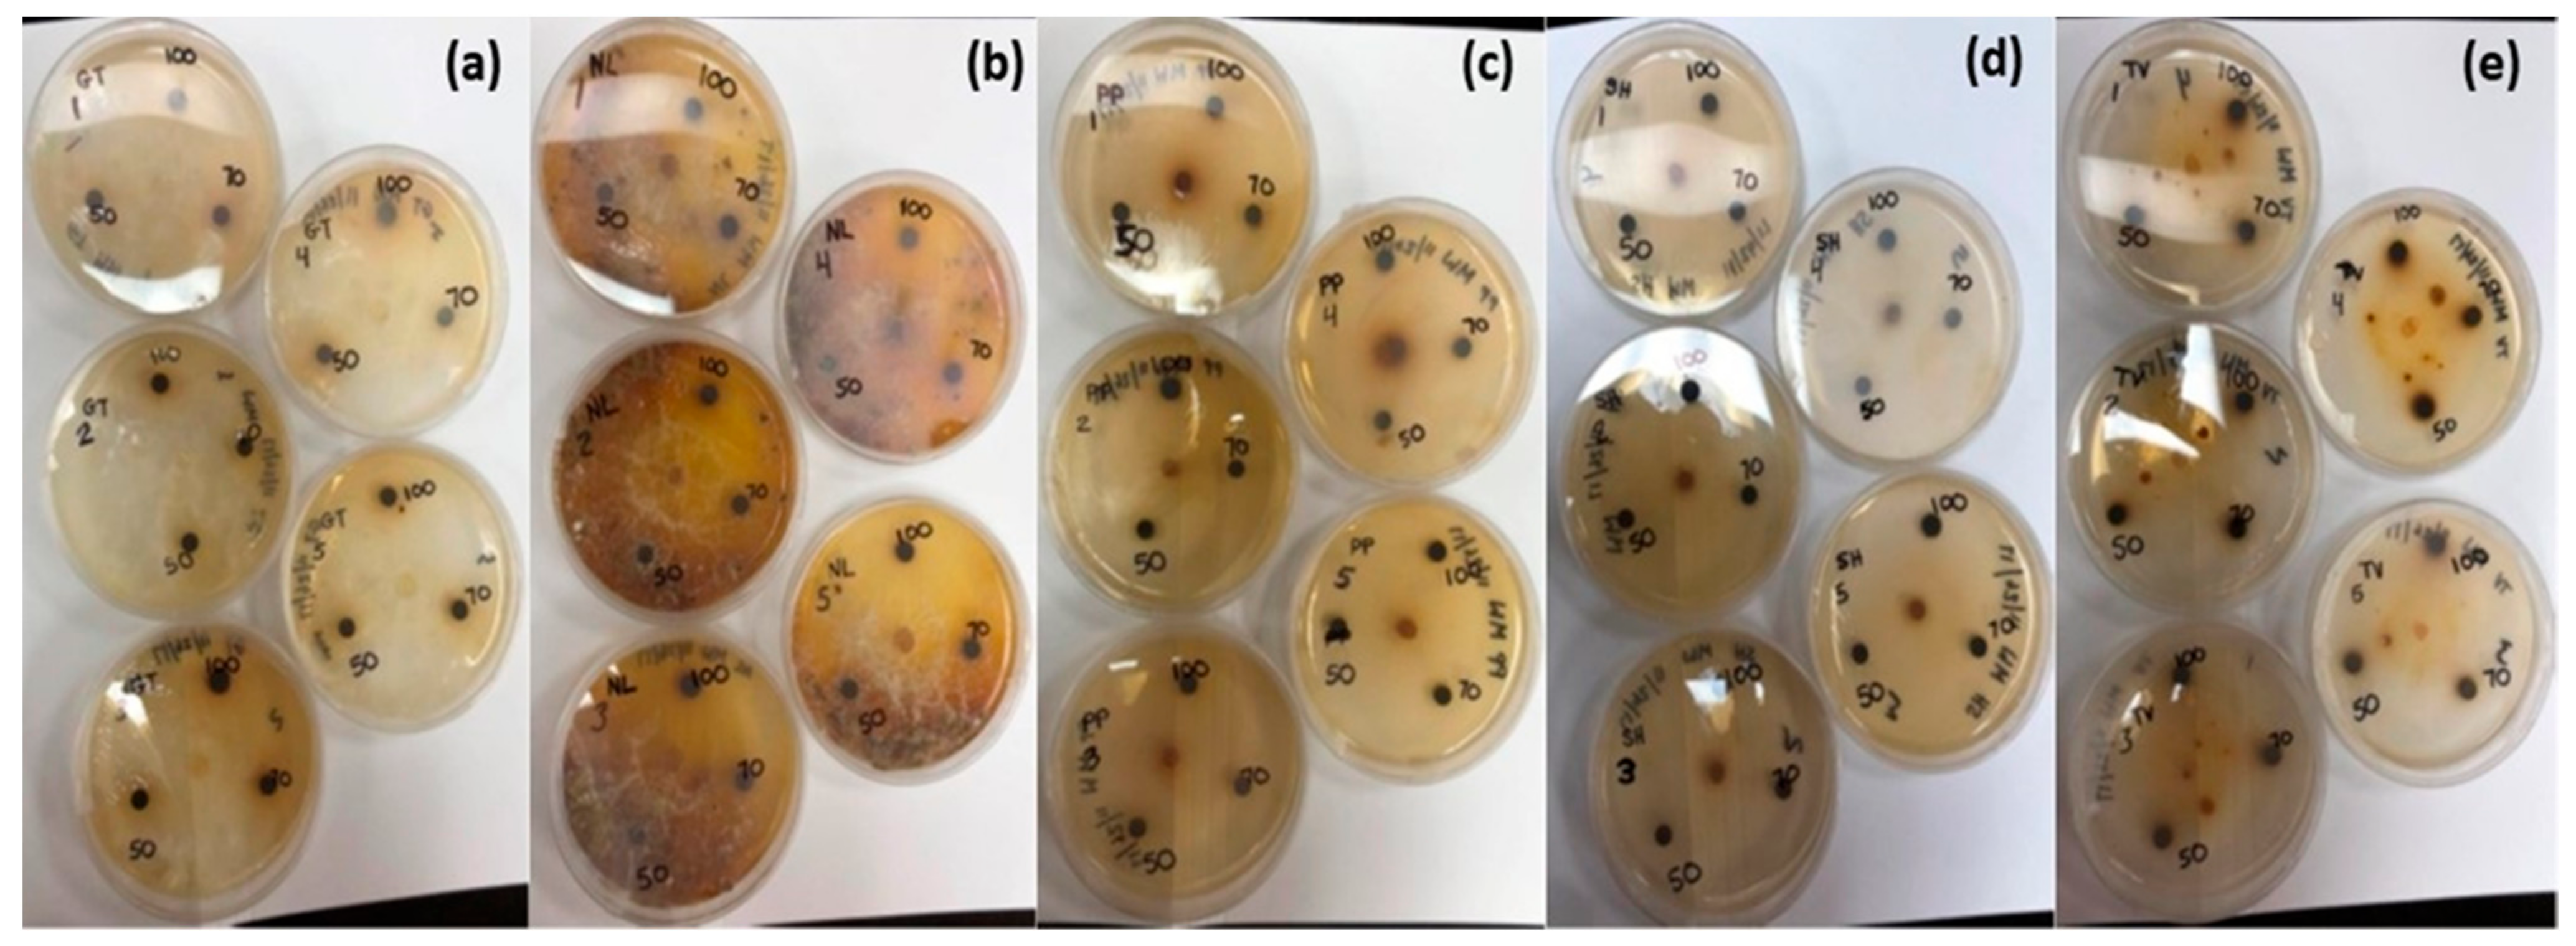
Forests 14 00625 g003 Forests 14 00625 g003

Fungal Resistance and Leaching Behavior of Wood Treated with Creosote Diluted with a Mixture of Biodiesel and Diesel
Abstract
1. Introduction
2. Materials and Methods
2.1. Chemicals and Materials
2.2. Pilot Plant Setup for Wood Preservative Treatment
2.3. Fungal Decay Test
2.3.1. Selection of Test Fungi and Its Inoculation
2.3.2. Wooden Block Preparation and Decay Test Setup
2.4. Agar Study for Testing the Efficacy of Creosote
2.5. Leaching Test
2.6. Analytical Methods
2.6.1. Measurement of Wooden Block Decay over Time
2.6.2. Statistical Analysis
3. Results and Discussion
3.1. Efficacy of Creosote Evaluated by Wood Blocks
3.2. Efficacy of Creosote Evaluated by Agar Test
3.3. Leaching Study of Creosote-Treated Wood
4. Conclusions
Supplementary Materials
Author Contributions
Funding
Data Availability Statement
Conflicts of Interest
References
- Cardarelli, F. Timbers and Woods. In Materials Handbook; Springer: Cham, Switzerland, 2018; pp. 1441–1464. [Google Scholar]
- Nilsson, T. 10 Biological Wood Degradation. In Wood Chemistry and Biotechnology; De Gruyter: Berlin, Germany, 2009; p. 219. [Google Scholar]
- Jones, A.S.; Marini, J.; Solo-Gabriele, H.M.; Robey, N.M.; Townsend, T.G. Arsenic, copper, and chromium from treated wood products in the US disposal sector. Waste Manag. 2019, 87, 731–740. [Google Scholar] [CrossRef] [PubMed]
- Betts, W.D. Information about coal-tar creosote for wood. In Proceedings of the International Tar Conference, Paris, France, 12 November 1990. [Google Scholar]
- Schulz, G. Die Bedeutung des Teeröls für die Holzkonservierung und die Notwendigkeit einer Harmonisierung der Lieferbedingungen. Holz Als Roh-Und Werkst. 1983, 41, 387–391. [Google Scholar] [CrossRef]
- Becker, L.; Matuschek, G.; Lenoir, D.; Kettrup, A. Leaching behaviour of wood treated with creosote. Chemosphere 2001, 42, 301–308. [Google Scholar] [CrossRef] [PubMed]
- Bolin, C.A.; Smith, S.T. Life cycle assessment of creosote-treated wooden railroad crossties in the US with comparisons to concrete and plastic composite railroad crossties. J. Transp. Technol. 2013, 3, 149–161. [Google Scholar] [CrossRef]
- Gallacher, C.; Thomas, R.; Taylor, C.; Lord, R.; Kalin, R.M. Comprehensive composition of Creosote using comprehensive two-dimensional gas chromatography time-of-flight mass spectrometry (GCxGC-TOFMS). Chemosphere 2017, 178, 34–41. [Google Scholar] [CrossRef] [PubMed]
- Singh, P.; Jain, R.; Srivastava, N.; Borthakur, A.; Pal, D.B.; Singh, R.; Madhav, S.; Srivastava, P.; Tiwary, D.; Mishra, P.K. Current and emerging trends in bioremediation of petrochemical waste: A review. Crit. Rev. Environ. Sci. Technol. 2017, 47, 155–201. [Google Scholar] [CrossRef]
- Li, C.; Zhou, K.; Qin, W.; Tian, C.; Qi, M.; Yan, X.; Han, W. A review on heavy metals contamination in soil: Effects, sources, and remediation techniques. Soil Sediment Contam. Int. J. 2019, 28, 380–394. [Google Scholar] [CrossRef]
- Kim, J.Y.; Oh, S.; Park, Y.K. Overview of biochar production from preservative-treated wood with detailed analysis of biochar characteristics, heavy metals behaviors, and their ecotoxicity. J. Hazard. Mater. 2020, 384, 121356. [Google Scholar] [CrossRef] [PubMed]
- Vaughan, J.A. Charactristics and related toxicity of hydrocarbon oils. Am. Wood-Preserv. Assoc. 1947, 43, 109–120. [Google Scholar]
- Nicholas, D.D. The influence of formulations on wood preservative performance. In Proceedings of the Annual Meeting-American Wood-Preservers’ Association, Scottsdale, AZ, USA, 17–20 May 1998. [Google Scholar]
- Barnes, H.M.; Amburgey, T.L.; Sanders, M.G. The impact of test site and oil content on the performance of pentachlorophenol-treated wood. For. Prod. J. 2006, 56, 43. [Google Scholar]
- Zhang, X.; Peterson, C.; Reece, D.; Haws, R.; Möller, G. Biodegradability of biodiesel in the aquatic environment. Trans. ASAE 1998, 41, 1423. [Google Scholar] [CrossRef]
- Schleicher, T.; Werkmeister, R.; Russ, W.; Meyer-Pittroff, R. Microbiological stability of biodiesel–diesel-mixtures. Bioresour. Technol. 2009, 100, 724–730. [Google Scholar] [CrossRef] [PubMed]
- Langroodi, S.K. Efficacy and Biodegradability of Pentachlorophenol in Conventional and Biodiesel Amended Carriers. Ph.D. Thesis, Mississippi State University, Starkville, MS, USA, 2012. [Google Scholar]
- Morrell, J.J.; Freitag, C. Effect of Biodiesel in# 2 Diesel on the Performance of Copper Naphthenate; Oregon State University: Corvalis, OR, USA, 2010. [Google Scholar]
- Langroodi, S.K.; Borazjani, H.; Nicholas, D.D.; Prewitt, L.M.; Diehl, S.V. Efficacy of pentachlorophenol in biodiesel versus diesel. For. Prod. J. 2012, 62, 467–473. [Google Scholar] [CrossRef]
- McKillop, N. Evaluating the Effect of Biodiesel on the Efficacy of the Wood Preservative Copper Naphthenate. Ph.D. Thesis, Dalhousie University, Halifax, NS, Canada, 2014. [Google Scholar]
- Encinar, J.M.; Gonzalez, J.F.; Rodríguez-Reinares, A. Biodiesel from used frying oil. Variables affecting the yields and characteristics of the biodiesel. Ind. Eng. Chem. Res. 2005, 44, 5491–5499. [Google Scholar] [CrossRef]
- Ramadhas, A.S.; Jayaraj, S.; Muraleedharan, C. Biodiesel production from high FFA rubber seed oil. Fuel 2005, 84, 335–340. [Google Scholar] [CrossRef]
- British Standard EN 113:1997; Wood Preservatives–Test Method for Determining the Protective Effectiveness against Wood Destroying Basidiomycetes–Determination of the Toxic Values. British Standards Institution: London, UK, 2004.
- AWPA E10-16; Laboratory Method for Evaluating the Decay Resistance of Wood-Based Materials Against Pure Basidiomycetes Cultures: Soil/Block Test. AWPA Book of Standards; American Wood Protection Association [AWPA]: Birmingham, AL, USA, 2016.
- Cappellazzi, J.; Maguire, K.; Nelson, R.; Morrell, J.J. Incidence of decay in creosote-treated Scots pine poles in Ireland. Holzforschung 2018, 72, 1079–1086. [Google Scholar] [CrossRef]
- Guillén, Y.; Navias, D.; Machuca, Á. Tolerance to wood preservatives by copper-tolerant wood-rot fungi native to south-central Chile. Biodegradation 2009, 20, 135–142. [Google Scholar] [CrossRef] [PubMed]
- Schmidt, O. Wood and Tree Fungi; Springer: Berlin/Heidelberg, Germany, 2006; p. 334. [Google Scholar]
- AWPA E11-16; Standard Method for Accelerated Evaluation of Preservative Leaching. AWPA Book of Standards; American Wood Protection Association [AWPA]: Birmingham, AL, USA, 2020.
- Osborn, L. Wettest Weather. Canada’s Raniest Cities. Current Results: Weather and Science Facts. 2018. Available online: https://www.currentresults.com/Weather-Extremes/Canada/wettest-cities.php (accessed on 9 September 2022).
- SAS Institute Inc. Means versus LS-Means. In SAS/SAT® 9.2 User’s Guide; SAS Institute Inc.: Cary, NC, USA, 2008. [Google Scholar]
- Zabel, R.A.; Morrell, J.J. Decay and Its Prevention; Academic Press Inc.: Cambridge, UK, 1992. [Google Scholar]
- Canadian Council of Ministers of the Environment [CCME]. Sediment Quality Guidelines for the Protection of Aquatic Life Summary Table; Canadian Council of Ministers of the Environment: Winnipeg, MB, Canada, 1999. [Google Scholar]
- Risk Based Corrective Action [RBCA]. Guidelines for Laboratories Tier 1 and Tier 2 Petroleum Hydrocarbons Methods; Version 3.1.; Risk Based Corrective Action: Fredericton, NB, Canada, 2016.

| Fungi Species | Creosote Concentration (%) | Mass Loss (%) | Standard Deviation | Mass Loss (%) LS Means * | LS Means Multiple Means Comparison ** |
|---|---|---|---|---|---|
| GT | 0 | 12.13 | 4.67 | 12.12 | B |
| GT | 50 | 5.86 | 0.73 | 5.86 | D |
| GT | 70 | 5.99 | 0.21 | 5.99 | D |
| GT | 100 | 5.96 | 0.41 | 5.97 | D |
| NL | 0 | 9.71 | 1.79 | 9.71 | BC |
| NL | 50 | 6.42 | 0.47 | 6.47 | D |
| NL | 70 | 5.95 | 0.88 | 5.95 | D |
| NL | 100 | 6.05 | 0.305 | 6.05 | D |
| RP | 0 | 7.33 | 3.57 | 7.11 | CD |
| RP | 50 | 5.94 | 0.27 | 6.005 | D |
| RP | 70 | 6.28 | 2.99 | 6.36 | D |
| RP | 100 | 6.27 | 0.19 | 6.27 | D |
| SH | 0 | 4.35 | 1.01 | 4.23 | D |
| SH | 50 | 6.03 | 0.19 | 6.06 | D |
| SH | 70 | 6.15 | 0.34 | 6.12 | D |
| SH | 100 | 6.07 | 1.04 | 6.07 | D |
| TV | 0 | 17.27 | 4.15 | 17.26 | A |
| TV | 50 | 6.90 | 1.45 | 5.93 | D |
| TV | 70 | 6.81 | 0.61 | 6.81 | D |
| TV | 100 | 6.75 | 0.43 | 6.74 | D |
| Fungi Species | Creosote Concentration (%) | Tukey’s Test ** |
|---|---|---|
| GT | 0 | A |
| GT | 50 | B |
| GT | 70 | B |
| GT | 100 | B |
| NL | 0 | A |
| NL | 50 | B |
| NL | 70 | B |
| NL | 100 | B |
| RP | 0 | A |
| RP | 50 | A |
| RP | 70 | A |
| RP | 100 | A |
| SH | 0 | A |
| SH | 50 | A |
| SH | 70 | A |
| SH | 100 | A |
| TV | 0 | A |
| TV | 50 | B |
| TV | 70 | B |
| TV | 100 | B |
| Sample | Concentration (mg/kg) | Standard Deviation | Sample Size |
|---|---|---|---|
| PAHs Before | 39,088 | 10,171 | 8 |
| PAHs After | 34,583 | 8311 | 8 |
| TPHs Before | 8396 | 1902 | 8 |
| TPHs After | 7699 | 2006 | 8 |
| Sample | Average Concentration (mg/kg) | Standard Deviation | Sample Size |
|---|---|---|---|
| PAH Sample 1 | 8.206 | 2.720 | 8 |
| PAH Sample 2 | 8.756 | 2.674 | 8 |
| TPH Sample 1 | 57.28 | 16.94 | 8 |
| TPH Sample 2 | 58.09 | 16.39 | 8 |
Disclaimer/Publisher’s Note: The statements, opinions and data contained in all publications are solely those of the individual author(s) and contributor(s) and not of MDPI and/or the editor(s). MDPI and/or the editor(s) disclaim responsibility for any injury to people or property resulting from any ideas, methods, instructions or products referred to in the content. |
© 2023 by the authors. Licensee MDPI, Basel, Switzerland. This article is an open access article distributed under the terms and conditions of the Creative Commons Attribution (CC BY) license (https://creativecommons.org/licenses/by/4.0/).
Share and Cite
Walker, K.; Rajput, H.; Murray, A.; Stratton, G.W.; Murray, G.; He, Q. Fungal Resistance and Leaching Behavior of Wood Treated with Creosote Diluted with a Mixture of Biodiesel and Diesel. Forests 2023, 14, 625. https://doi.org/10.3390/f14030625
Walker K, Rajput H, Murray A, Stratton GW, Murray G, He Q. Fungal Resistance and Leaching Behavior of Wood Treated with Creosote Diluted with a Mixture of Biodiesel and Diesel. Forests. 2023; 14(3):625. https://doi.org/10.3390/f14030625
Chicago/Turabian StyleWalker, Kathleen, Himadri Rajput, Alexander Murray, Glenn W. Stratton, Gordon Murray, and Quan (Sophia) He. 2023. "Fungal Resistance and Leaching Behavior of Wood Treated with Creosote Diluted with a Mixture of Biodiesel and Diesel" Forests 14, no. 3: 625. https://doi.org/10.3390/f14030625
APA StyleWalker, K., Rajput, H., Murray, A., Stratton, G. W., Murray, G., & He, Q. (2023). Fungal Resistance and Leaching Behavior of Wood Treated with Creosote Diluted with a Mixture of Biodiesel and Diesel. Forests, 14(3), 625. https://doi.org/10.3390/f14030625

